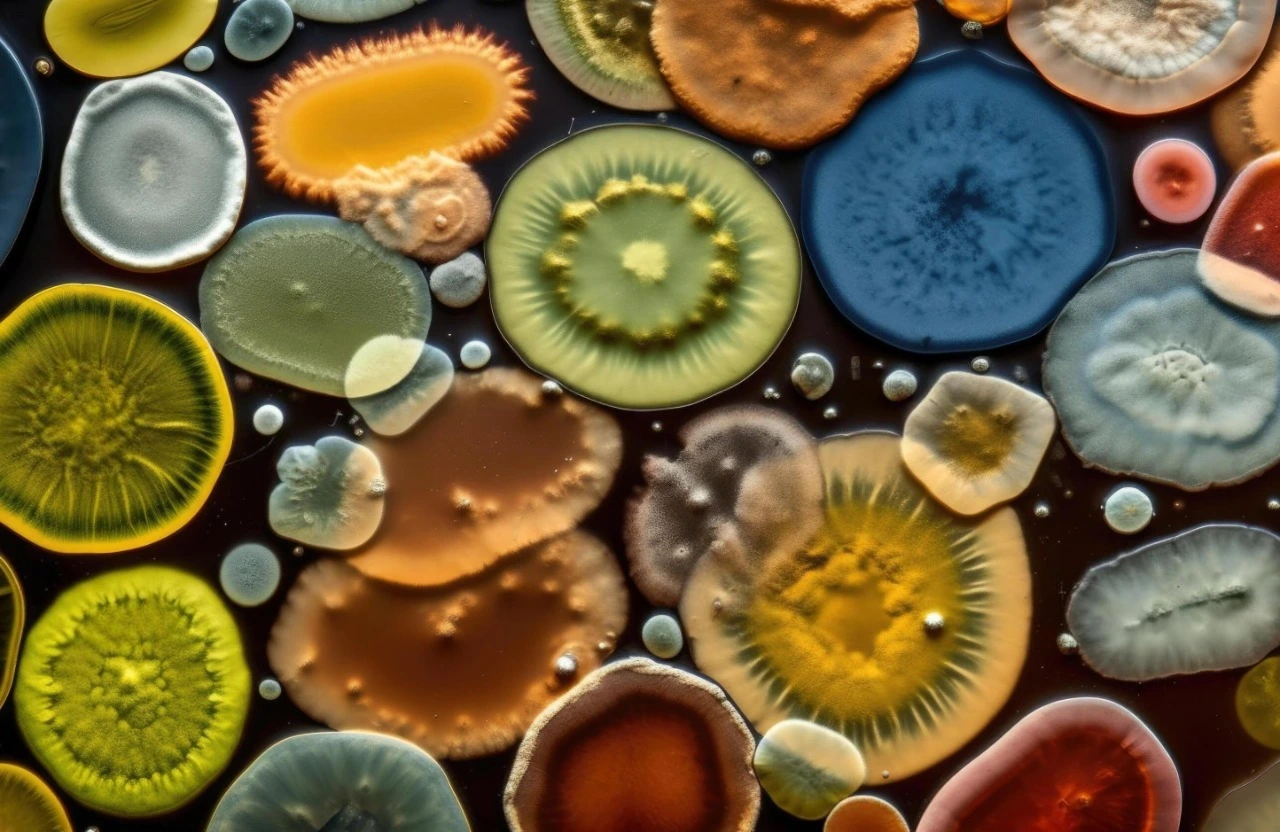

Biotechnology is enabling innovation far beyond biopharma, delivering cleaner water, purifying the air we breathe, eliminating forever chemicals from ecosystems, and providing innovative ways to sustainably produce food, materials, and energy.

Integrating computational and experimental approaches to map, understand, and engineer complex biological systems.

Precision bioengineering tools enabling faster, and more dynamic gene editing, unlocking new functions in organisms.

Improving and introducing novel metabolic networks in microbes to biomanufacture food, fuels, and high-value bioproducts.

Revolutionizing biotech research by increasing the experimental output in bioengineering workflows.
In a world with rapidly increasing costs, carbon emissions, and concern for where our everyday products come from, bioproduction has an answer. Scientists and bioprospectors are scouring the globe for useful microbes that have already unlocked other-worldy capabilities: textiles from trash, food with 99% less land use, a rewilding of the nature our ancestors degraded. Not only can precision fermentation deliver on these outlandish futures, but it has already provided antibiotics for the sick. Penniclin, the first antibiotic that’s saved millions if not billions of lives, was found in a natural fungus. Scientists and engineers then worked tirelessly to scale production of this miracle drug. Today the next revolution in fermentation is bringing us new detergents, new fuels, new foods, safer dyes, and natural pesticides at industrial scales. At ValleyDAO we’re investing in this future, where little workhorses create earth-friendly products for everyday use.
If interested in a deep-dive on this up-and-coming industry check out this Nature Review.

Cocoa ZERO makes real chocolate taste using precision fermentation, not faraway plantations. We grow cocoa lipids locally in steel tanks, 90 percent matched to cocoa butter, then blend with sustainable beans for bars that melt like classic chocolate with a lighter footprint and a more reliable supply.
$300,000
Crowdfunded

Biology is the new engineering, but strain design is still slow and fragmented. SynbioCAD unifies the computational toolkit, from target molecule to lab ready experiments, with AI that ranks pathways and a cell-free platform that tests and validates the most promising bioproduction routes. Bioengineering teams cut design time from months to weeks and move to build with confidence.
Currently in Incubation